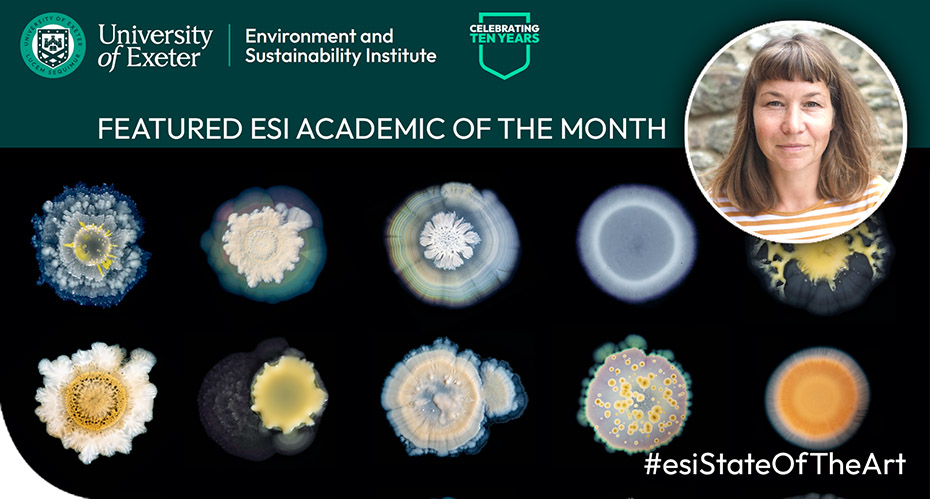

- Home
- Our institutes
- Environment and Sustainability Institute
- News and events
- ESI Academic of the Month
ESI Academic of the Month
Dr Tiago de Melo Cartaxo, Senior Lecturer in Environmental Law and an Associate Director for External Engagement at the ESI, was our Featured Academic for June 2024!
Relevant research
Dr Tiago de Melo Cartaxo and colleagues have a chapter "Energy Efficiency as a Tool for Energy Poverty Reduction: A Legal Perspective" in the Routledge Handbook of Energy Communities and Smart Cities.
The Exeter Centre for Environmental Law (ExCEL) at the Exeter Law School Cornwall, is exploring the potential for Cornwall and Isles of Scilly to become a UNESCO Biosphere Reserve. This work was supported by Research England's Policy Support Fund (PSF). Dr Tiago de Melo Cartaxo was one of the applicants. Read more.
Dr Tiago de Melo Cartaxo has been a member of the Society of Legal Scholars, Biodiversity and People Network, ILA Committee on Sustainable Development and the Green Economy in International Trade Law, the ICC Commission on Environment and Energy and the Global Network for Human Rights and the Environment.
Arnold CAT, De Melo Cartaxo T. (2022) Resilience Justice and Adaptive Law in European Cities, Urban Climate Resilience: The Role of Law, Edward Elgar Publishing, 125-150.
Dr Tiago de Melo Cartaxo delivered the ESI State of the Art talk “Thinking (and acting) locally in the legal protection of the environment” on Monday 24 June 1 - 2pm in the ESI Trevithick Room.
Environmental problems and their consequences usually do not take into consideration country or regional borders. On the other hand, law and regulation can only be applied and enforced within a certain jurisdiction. International Environmental Law intends to address, and at least minimise, large-scale problems across the world. However, its instruments are more based on aspirational provisions which are not easily enforced. National environmental legal frameworks usually are understood as the most effective ones, as they are composed of a wider combination of mechanisms which make it easier for public authorities and courts to apply them. Nonetheless, even within national jurisdictions there are different realities, landscapes, ecosystems, and social communities, which cannot be easily regulated in the same way. This talk intends to analyse examples of how local and place-based legal mechanisms can contribute to the wider protection of the environment, including at the global level. Let us start locally!
View the video recording of his talk
Please note: From September 2024, we are rebranding the “ESI State of The Art” talks to “ESI Challenge of the Month.” In the former, the talks were focussed around the speaker’s career. For the Challege of the month, we now hope to put the emphasis on the broader environmental challenge that is being tackled through their research.
Previous featured academics

Professor Karen Hudson-Edwards, Professor in Sustainable Mining is our Featured Academic for September 2020!
Click here to view her profile page.
Karen Hudson-Edwards was one of the speakers at the 4th September Camborne School of Mines Business Breakfast, where the theme was Tailings: Updates from QUEX (The Universities of Queensland and Exeter).
Karen was also part of the “Space Technology in Extreme Mining Environments” held on 8th September. This was a collaborative event between South West Centre of Excellence in Satellite Applications (SWCoESA), Satellite Applications Catapult, MineSense and Exeter Extreme Environments. It summarised the challenges faced in working in extreme mining environments, and how satellite technology can help to solve these challenges.
Some of her newest publications:
Riley, A.L., MacDonald, J.M., Burke, I.T., Renforth, P., Jarvis, A.P., Hudson-Edwards, K.A., McKie, J., Mayes, W.M. (2020) Legacy iron and steel wastes in the UK: Extent, resource potential and management futures. Journal of Geochemical Exploration, 219, 106630.
Hubau, A., Guezennec, A.-G., Joulian, C., Falagan, C., Dew, D., Hudson-Edwards, K.A. (2020) Bioleaching to reprocess sulfidic polymetallic primary mining residues: Determination of metal leaching mechanisms. Hydrometallurgy, 197, 105484.
Li, W., Liu, J., Hudson-Edwards, K.A. (2020) Seasonal variations in arsenic mobility and bacteria diversity of Huangshui Creek, Shimen Realgar Mine, Hunan Province, China. Science of the Total Environment, 749, 142353.
The European Association of Geochemistry selected Karen as The Distinguished Lecturer 2019.
This program aims to introduce and motivate scientists and students located in under-represented regions of the world to emerging research areas in geochemistry. The Distinguished Lecturer is selected each year based on a combination of outstanding research contributions to geochemistry and the ability to clearly communicate these contributions to a broad audience.
View her lectures from last years Distinguished Lecturer tour:
Karen gave the inaugural State of the Art talk “Exeter Extreme: The New University Hub and Examples from Mine Waste Environments” on Monday 28th September 1 – 2pm.
Extreme environments are spaces or habitats with harsh or severe conditions. The extremes encountered include those respect to radiation, acidity or alkalinity, pollution, temperature, salinity or lack of oxygen or water, disease, political stability, equity, economic status, safety and others. ’Exeter Extreme’ is a new university hub that aims to apply the lessons learned from research on extremes to prepare us for the extreme present and extreme futures. This presentation will introduce the Exeter Extreme hub, and illustrate this with examples from Karen Hudson-Edwards’ research on mine wastes, which are themselves extreme environments and host extreme organisms.

Dr Tomas Chaigneau, Senior Lecturer in Social Sciences for our Environment is our Featured Academic for October 2020!
Click here to view his profile page.
Tomas Chaigneau has recently been funded as Co-I (20%) on a FORMAS (Swedish research council) grant worth in total approximately £1,760,500. Carl Folke, Tomas Chaigneau. Anne-Sophie Crepin. Maike Hamann, Robert Heilmayr, Patrik Henriksson, Emilie Lindkvist, Juan Rocha Gordo, Caroline Schill, Andrew Tilman and Tong Wu: “Inequality and the Biosphere: Achieving the Sustainable Development Goals in an unequal world” The project aims to identify synergies and trade-offs between reducing inequalities (SDG 10) and safeguarding the biosphere (SDGs 14 and 15). It will aim to identify patterns between different types of inequality and environmental indicators, understand the processes through which inequalities influences environmental behaviours and engage with stakeholders in across scales to identify practices that can harness win/win interactions between SDGs while minimizing trade-offs.
Leading up to Tomas Chaigneau’s #esiStateOfTheArt talk, read his paper about ‘Inequality and the Biosphere’ in the Annual Review of Environment and Resources.
“Whilst behavioural economics research has provided critical insights into understanding and predicting environmental behaviours, an important consideration that remains largely unexplored is to what extent people behave differently given their differing wellbeing and poverty levels. This is particularly important when considering sustainable development which not only strives for environmental sustainability of marine and land based resources but also seeks to address inequality and the eradication of poverty in all its forms. There is a need to further expand our understanding of human behaviours by bringing together a large body of work from the social sciences on human wellbeing with insights from behavioural economics.”
Tomas gave the State of the Art talk “Striving for sustainability in an unequal world” on Monday 26th October 1 – 2pm.
Inequality is one of the key social challenges of our time. Reducing inequality is not only a policy target for many nations but can also impact the biosphere, and as such, can shape the achievement of sustainable development goals. However, remarkably little work has sought to understand the effect of inequalities on the natural environment. This talk will explore what work has been done to date on inequalities (in both natural and social systems) and its role in shaping environmental sustainability and introduce some preliminary findings and ongoing research on the topic. It will identify some of the key disciplines and concepts from the natural and social sciences that could start to unravel this complex link further, and discuss the merits of future research in such an unexplored research topic.
Click here to view the full video from his talk.

Dr Xiaoyu Yan, Senior Lecturer in Energy and Environment is our Featured Academic for November 2020!
Click here to view his profile page.
A new four-year project ‘GREENPEG’ has received a grant of €8.3 million from the European Union’s Horizon 2020 research and innovation programme to develop new techniques to explore for pegmatite rocks containing lithium and other green technology metals. The University of Exeter team, which will receive nearly €780k, is led by Ben Williamson with Frances Wall, Camborne School of Mines and Xiaoyu Yan, Engineering, supported by post-doctoral researchers Kate Smith and Rob Pell.
https://www.exeter.ac.uk/esi/news/articles/newprojecttofindeuropesgre.php
The University of Exeter will lead a pioneering new research centre, designed to revolutionize how crucial metals are extracted, used and reused in clean and digital technologies across the UK. This project will be led by Frances Wall, along with Xiaoyu Yan, Karen Hudson-Edwards and other colleagues from Camborne School of Mines, the Environment and Sustainability Institute, the Renewable Energy department and the Business School.
https://www.exeter.ac.uk/news/research/title_825455_en.html
https://www.ukri.org/news/circular-economy-centres-to-drive-uk-to-a-sustainable-future/
Xiaoyu is leading the Circular and Low Impact Processed Food (CLIP) project funded by European Regional Development Fund through the Agri-Tech Cornwall programme. CLIP aims to develop a freely available tool that can help better understand and ultimately improve the environmental performance of processed food products, ensuring the sustainability of the sector in the medium and long-term. We will work with processed food manufacturers in Cornwall, in the first instance Cornish Pasty makers, create the tool in a way that can help these businesses improve existing products and design new products.
Read his paper on plastic bottle vs glass bottle in Cornwall.“It is crucial to consider the waste infrastructure and management practices in place and use life cycle thinking-based models to evaluate any solutions to plastics pollution in order to avoid problem shifting.”
https://www.sciencedirect.com/science/article/abs/pii/S0048969720321987?
A new publication in Energy Policy “Energy-food nexus in the marine environment: A macroeconomic analysis on offshore wind energy and seafood production in Scotland.”From a macroeconomic perspective, offshore wind farms have a negative, but limited, effect on seafood production sectors while having a positive impact on the economy overall and benefiting lower income households.
https://authors.elsevier.com/c/1c99R14YGgfKIs
Xiaoyu delivered the State of the Art talk “Quantifying environmental performance of human systems across socioeconomic scales” on Monday 30th November 1 – 2pm.
We, as a species, have managed to drastically degrade the environment (air, water and land) over the last couple of decades, endangering not only our own life support systems but also other species on Earth. In recent years, the tide seems to have turned, with individuals, communities, organisations and nations mobilising to take more action on pressing sustainability challenges such as climate change, air pollution and plastic waste. However, we need to have a holistic and quantitative understanding of the environmental implications of everything we do. Otherwise, how can we know if we are doing the right thing(s)? In this talk, I will explain the methods that are commonly used to quantify the environmental performance of defined human systems (e.g., a product, a household, an organisation, a sector etc) from a whole life cycle perspective. Examples from past and ongoing projects will be used to show that sometimes well-intentioned actions can result in unexpected and undesirable consequences. I will end by sharing some thoughts on future directions in this area.
Click here to view the full video from his talk.

Dr Anne Leonard, NERC Innovation Fellow, is our Featured Academic for January 2021!
Click here to view her profile page.
Read Anne Leonard's paper based on the findings from the Beach User Health Survey: A cross-sectional study on the prevalence of illness in coastal bathers compared to non-bathers in England and Wales in Water Research.
Read another relevant paper for her upcoming talk: Exposure to and colonisation by antibiotic-resistant E. coli in UK coastal water users: Environmental surveillance, exposure assessment, and epidemiological study (Beach Bum Survey) in Environment International.
Last year Anne and Isobel Stanton talked to Ellen Hussain on BBC Costing the Earth about their research done in collaboration with Aimee Murray, Lihong Zhang and Will Gaze. Listen to the podcast here "Swimming in Superbugs".
Her work was cited in the WHO’s recommendations to the Bathing Water Directive on maintaining safe bathing water quality, and in the Environment Agency’s 2020 report on health, people and the environment. The risks of human exposure to AMR in water were also referenced in the UK government’s 5-year AMR strategy, in which tackling AMR in the environment was identified as a priority.
Anne talked about the University of Exeter Medical School study which examined wehther we are exposed to antibiotic reistance in coastal waters.
View the full video here.
Anne delivered the State of the Art talk “Interdisciplinary approaches to understanding the spread of microbes and antimicrobial resistance in aquatic environments” on Monday 25th January 1 – 2pm.
Antimicrobials have been an important aspect of Western medicine in the management of infections since their manufacture and widespread use in the 1940s. However, antimicrobial resistance (the ability of microorganisms to survive and grow in the presence of antimicrobials) threatens our ability to manage the risks to health posed by microorganisms that cause infections. Until recently, research into the origins and spread of antimicrobial resistance has focused on the role of clinical settings and on microorganisms that cause infection. However, research is beginning to shed light on the important role that non-human, and particularly natural environments, play in the emergence, dissemination and transmission of resistance. This talk will describe recent and ongoing interdisciplinary research to understand the spread of microorganisms, particularly of antibiotic resistant bacteria, in aquatic environments associated with coastal bathing waters.
Click here to view the full video of the talk.

Prof Stuart Townley, Professor in Applied Mathematics, is our Featured Academic for February 2021!
Click here to view his profile page.
Here are some of the publications by Stuart:
Parfett, A., Townley, S. & Allerfeldt, K. AI-based healthcare: a new dawn or apartheid revisited?. AI & Soc (2020).
Modeling and analysis of COVID-19 epidemics with treatment in fractional derivatives using real data from Pakistan. PA Naik, M Yavuz, S Qureshi, J Zu, S Townley. The European Physical Journal Plus 135 (10), 1-42
Wave energy converter control by wave prediction and dynamic programming. G Li, G Weiss, M Mueller, S Townley, MR Belmont. Renewable Energy 48, 392-403
A framework for studying transient dynamics of population projection matrix models. I Stott, S Townley, DJ Hodgson. Ecology Letters 14 (9), 959-970
Identifying on admission patients likely to develop acute kidney injury in hospital. A Argyropoulos, S Townley, PM Upton, S Dickinson, AS Pollard. BMC nephrology 20 (1), 1-11
Stuart Townley has been very involved in our annual ESI Environment & Sustainability Day, organising workshops for Year 9 and 10 students. This is the cornerstone of our engagement with schools, organised in collaboration with the University’s widening participation team. Stuart and Markus Mueller produced a board game "Ocean Struggle: People, plastics and wildlife" for one of the workshops which got funded to be developed. It works on the probabilities of plastics in marine currents coming into contact with and causing damage to marine wildlife.

Our Featured ESI Academic of the month is not only an academic, he is also an artist! He participated in the ESI Creative Exchange programme in 2019. View his exhibition “Stuart Townley - The Mathematician and the Artist”.
Stuart Townley delivered the #esiStateOfTheArt talk “Mathematics - a language of collaboration” on Monday 22 February 2021 1 – 2pm.
My talk is in two parts. In the first part, I will draw on my collaborations over the last decade - since joining the ESI - to illustrate how mathematics can be used to connect disciplines, distil the key essence of a problem, or to explore an idea.This will span applications of mathematics in ecology, renewable energy and healthcare.
In the second part, I will discuss in more detail a recent and on-going collaboration between maths and arts & humanities, specifically work with Alice Parfett and Kris Allerfeldt in History. Here, we explore issues of privacy, and especially emergent prejudice, in AI systems. Using simple toy models of disease networks, we show that prejudice can emerge due to feedbacks between data collection (e.g. key health stats) and being "led by the data" in making decisions (e.g. who to vaccinate). I will draw parallels with emergence of prejudice in social systems. I will conclude with a discussion of similar issues for AI in other parts of society.
Click here to view the full video of the talk.

Dr Karen Anderson, Associate Professor in Remote Sensing, is our Featured Academic for March 2021!
Click here to view her profile page.
Here are some of the publications by Karen:
Read her recent paper “Drones provide spatial and volumetric data to deliver new insights into microclimate modelling” by James Duffy, Karen Anderson, Dominic Fawcett, Robin Curtis and Ilya Maclean in Landscape Ecology.
The WWF report on 'drones for conservation' was a collaborative piece written by Karen Anderson, James Duffy, Leon DeBell and co-authors from WWF. It's a free online textbook guide for anyone in conservation science who wants to learn about the hows/whys/wheres of using a drone 'in the wild'.
Karen's research which showed that plant life is expanding in the area around Mount Everest was featured in The Guardian, BBC News, and CNN. Even Leonardo DiCaprio tweeted about it! The paper, published in the journal Global Change Biology, is entitled: “Vegetation expansion in the subnival Hindu Kush Himalaya.” Karen Anderson and Dominic Fawcett are the first authors.
Carless, D., Luscombe, D. J., Gatis, N., Anderson, K., & Brazier, R. E. (2019). Mapping landscape-scale peatland degradation using airborne lidar and multispectral data. Landscape Ecology, 34(6), 1329-1345.
Hancock, S., Anderson, K., Disney, M., & Gaston, K. J. (2017). Measurement of fine-spatial-resolution 3D vegetation structure with airborne waveform lidar: Calibration and validation with voxelised terrestrial lidar. Remote Sensing of Environment, 188, 37-50.
Anderson, K., Hancock, S., Disney, M., & Gaston, K. J. (2016). Is waveform worth it? A comparison of Li DAR approaches for vegetation and landscape characterization. Remote Sensing in Ecology and Conservation, 2(1), 5-15.
Garrett, B., & Anderson, K. (2018). Drone methodologies: Taking flight in human and physical geography. Transactions of the Institute of British Geographers, 43(3), 341-359.
Anderson, K., Westoby, M. J., & James, M. R. (2019). Low-budget topographic surveying comes of age: Structure from motion photogrammetry in geography and the geosciences. Progress in Physical Geography: Earth and Environment. 2019;43(2):163-173.
Joyce KE, Anderson K, Bartolo RE. Of Course We Fly Unmanned—We’re Women! Drones. 2021; 5(1):21.
Ellis, N., Anderson, K., & Brazier, R. (2021). Mainstreaming natural flood management: A proposed research framework derived from a critical evaluation of current knowledge. Progress in Physical Geography: Earth and Environment, 0309133321997299.
Cunliffe, A. M., McIntire, C. D., Boschetti, F., Sauer, K. J., Litvak, M., Anderson, K., & Brazier, R. E. (2020). Allometric relationships for predicting aboveground biomass and sapwood area of oneseed Juniper (Juniperus monosperma) trees. Frontiers in plant science, 11, 94.
Karen Anderson delivered the #esiStateOfTheArt talk “From leaf to landscape - state-of-the-art remote sensing for monitoring ecosystem dynamics” on Monday 29 March 2021 1 – 2pm.
Remote sensing is the science of measuring the dynamics of Earth systems using sensors onboard platforms such as satellites, airplanes or drones. In her research, Karen uses data spanning all such scales to query and quantify dynamics in terrestrial ecosystems, with a particular focus on eco-hydrology (the interactions between plants and the water cycle) and carbon-cycle related processes. She works predominantly in low biomass systems such as drylands and mountain ecosystems where plants can exert profound impacts on carbon/water processes.
In her 'state of the art' talk, Karen will use examples from her own research to provide examples of new approaches in remote sensing in action. The talk will start at low altitude, exploring applications for drone technology in improving biomass estimates in short-stature ecosystems via digital photogrammetry; then will move to higher elevations where examples of airborne laser scanning will be explained, and finally - to space and innovations in the remote sensing 'cloud' where big data questions about vegetation dynamics across huge ecosystems (in this case, the Himalaya) can be addressed.
Click here to view the full video of the talk.

Dr Senthil Sundaram, Senior Lecturer in Renewable Energy, is our Featured Academic for May 2021!
Click here to view his profile page.
Roy, A., Sundaram, S., & Mallick, T. (2021). Effect of dye sensitization’s temperature on ZnO-based solar cells. Chemical Physics Letters (in press)
Velusamy, S., Roy, A., Sundaram, S., & Mallick, T. K. A Review on Heavy Metal Ions and Containing Dyes Removal Through Graphene Oxide-Based Adsorption Strategies for Textile Wastewater Treatment. The Chemical Record.
Bhandari, S., Roy, A., Ghosh, A., Mallick, T. K., & Sundaram, S. (2020). Perceiving the temperature coefficients of carbon-based perovskite solar cells. Sustainable Energy & Fuels, 4(12), 6283-6298.
Khalid, M.; Roy, A.; Bhandari, S.; Sundaram, S.; Mallick, T.K. Integrating Concentrated Optics for Ambient Perovskite Solar Cells. Energies 2021, 14, 2714.
Roy, A., Ghosh, A., Benson, D., Mallick, T. K., & Sundaram, S. (2020). Emplacement of screen-printed graphene oxide coating for building thermal comfort discernment. Scientific reports, 10(1), 1-13.
Khalid, M.; Roy, A.; Bhandari, S.; Sundaram, S.; Mallick, T.K. Integrating Concentrated Optics for Ambient Perovskite Solar Cells. Energies 2021, 14, 2714.
The contributory book chapter titled "Concern for Heavy Metal-ion Water Pollution: Their Strategic Detection and Removal Opportunities" by Sasisreka Velusamy, Anurag Roy, Senthilarasu Sundaram and Tapas K. Mallick was recently accepted in Legacy, Pathogenic and Emerging Contaminants in the Environment published by CRC Press, Taylor, and Francis. (In Press)
Dr Senthil Sundaram delivered the #esiStateOfTheArt talk “Finding a holy grail material to fix the world's Energy Needs” on Monday 24 May 2021 1 – 2pm.
The energy needs of society are increasing day by day. Making energy generation sustainable and carbon-free is challenging. My research is focusing on finding suitable materials to address green energy generation and storage. Mainly address the stability of the most efficient solar cells for energy conversion, having high-density thermal storage materials and materials for environmental applications. The perovskite solar cells with high conversion efficiency and its scaling up engineering of the devices into the commercial level, using carbon materials for water distillation and heavy metal pollution removal and addressing industrial wastage heat management is also part of our group research.
Click here to view the full video of the talk.

Prof Edze Westra, Professor/ NERC Independent Research Fellow, was our Featured Academic for July 2021!
Click here to view his profile page.
Some of his key publications:
Rollie, C., Chevallereau, A., Watson, B.N.J. et al. Targeting of temperate phages drives loss of type I CRISPR–Cas systems. Nature 578, 149–153 (2020). https://doi.org/10.1038/s41586-020-1936-2
Westra, E. R., van Houte, S., Oyesiku-Blakemore, S., Makin, B., Broniewski, J. M., Best, A., ... & Buckling, A. (2015). Parasite exposure drives selective evolution of constitutive versus inducible defense. Current biology, 25(8), 1043-1049.
van Houte, S., Ekroth, A. K., Broniewski, J. M., Chabas, H., Ashby, B., Bondy-Denomy, J., ... & Westra, E. R. (2016). The diversity-generating benefits of a prokaryotic adaptive immune system. Nature, 532(7599), 385-388.
Landsberger, M., Gandon, S., Meaden, S., Rollie, C., Chevallereau, A., Chabas, H., ... & van Houte, S. (2018). Anti-CRISPR phages cooperate to overcome CRISPR-Cas immunity. Cell, 174(4), 908-916.
Alseth, E. O., Pursey, E., Luján, A. M., McLeod, I., Rollie, C., & Westra, E. R. (2019). Bacterial biodiversity drives the evolution of CRISPR-based phage resistance. Nature, 574(7779), 549-552.
Prof Edze Westra is a Finalist for the Blavatnik Awards for Young Scientists 2021 in the Life Sciences category.
He was also a finalist last year.
View the 'Meet the 2020 Blavatnik Awards UK Life Sciences Honorees' video.
Other awards:
Edze Westra was a Philip Leverhulme Prize winner in Biological Sciences in 2020.
In the same year, he was also the Fleming Prize winner!
In 2016, he received the Heineken Young Investigator Award by the Dutch Royal Society for Science.
Prof Edze Westra was one of the speakers at the 3 day University of Exeter Microbiology Symposium in February 2021.
View his talk.
Prof Westra delivered the #esiStateOfTheArt talk “Viruses of microbes - key players in anything from ecosystem functioning to human health and disease” on Monday 5 July 2021 1 – 2pm.
Bacterial viruses (phages) shape the composition and evolution of microbial communities in nature and therefore play important roles in ecosystem functioning. This view stems from the 1990-2000s which revealed high viral abundance, diversity and virus-induced mortality in aquatic ecosystems as well as an association between collapses in bacterial density and peaks in phage abundance. The recent surge in metagenomics analyses has provided deeper insight into the abundance, genomic diversity and spatiotemporal dynamics of phages in a wide variety of ecosystems, ranging from deep oceans to soil and the mammalian digestive tract. However, the causes and consequences of variations in phage community compositions remain poorly understood. I will discuss our current knowledge on the composition and evolution of phage communities, as well as their roles in controlling the population and evolutionary dynamics of microbial communities in natural ecosystems and the human microbiome..
Click here to view the full video of the talk.

Dr Laura Newsome, Lecturer in Geomicrobiology, was our Featured Academic for September 2021!
Click here to view her profile page.
Some of her key publications:
Newsome, L., & Rodriguez, C. F. (2021). The microbiology of metal mine waste: bioremediation applications and implications for planetary health. GeoHealth (accepted)
Newsome, L., Bacon, C. G., Song, H., Luo, Y., Sherman, D. M., & Lloyd, J. R. (2021). Natural attenuation of lead by microbial manganese oxides in a karst aquifer. Science of the Total Environment, 754, 142312.
Lopez-Adams, R., Newsome, L., Moore, K. L., Lyon, I. C., & Lloyd, J. R. (2021). Dissimilatory Fe (III) Reduction Controls on Arsenic Mobilization: A Combined Biogeochemical and NanoSIMS Imaging Approach. Frontiers in microbiology, 12, 219.
Newsome, L., Arguedas, A. S., Coker, V. S., Boothman, C., & Lloyd, J. R. (2020). Manganese and cobalt redox cycling in laterites; Biogeochemical and bioprocessing implications. Chemical Geology, 531, 119330. View the blog and an explanatory video.
Newsome, L., Morris, K., Cleary, A., Masters-Waage, N. K., Boothman, C., Joshi, N., ... & Lloyd, J. R. (2019). The impact of iron nanoparticles on technetium-contaminated groundwater and sediment microbial communities. Journal of hazardous materials, 364, 134-142.
Newsome, L., Lopez Adams, R., Downie, H. F., Moore, K. L., & Lloyd, J. R. (2018). NanoSIMS imaging of extracellular electron transport processes during microbial iron (III) reduction. FEMS microbiology ecology, 94(8), fiy104.
This research was top of the table for FEMS Microbial Ecology Altmetric scores in 2018!
Relevant talks.
Hear Laura Newsome's talk at the Royal Cornwall Geological Society back in May 2021 titled "Geomicrobiology - how microbes change the world."
Laura gave the talk "Microbe-metal interactions in extreme environments" at the Microbiology Symposium earlier this year.
Other.
Laura Newsome, along with Tomasa Sbaffi and Carmen Falagan Rodriguez, collaborated with artist Hugo Glasier with the ESI Creative Exchange exhibition titled "Hidden in Plain Sight." This was a photographic journey into the subsurface of Cornwall’s mining heritage.
Dr Laura Newsome is also the chair of the Environmental Mineralogy Group (EMG) of the Mineralogical Society of Great Britain & Ireland. View their science outreach competition where you could win £300 by submitting a short video of your favourite mineral !
Dr Laura Newsome delivered the #esiStateOfTheArt talk “Small but Mighty: How Microbes change the Earth” on Monday 27 September 2021 1 – 2pm.
Although microbes are very small, their metabolism changes the world, both in the present day and the geological past. This talk will introduce the field of geomicrobiology and show how we can use cutting edge microscopy and spectroscopy to elucidate the ways in which microbes interact with minerals and can clean up pollution. I will also highlight some of my ongoing research into exciting and unusual environments where I have found microbes in Cornwall.
Click here to view the full video of the talk.

Dr David Baker, Research Fellow in Ecology, was our Featured Academic for October 2021!
Click here to view his profile page
Some of his recent publications:
Baker, D. J., Dickson, C. R., Bergstrom, D. M., Whinam, J., Maclean, I. M., & McGeoch, M. A. (2021). Evaluating models for predicting microclimates across sparsely vegetated and topographically diverse ecosystems. Diversity and Distributions.
Baker, D. J., Maclean, I. M., Goodall, M., & Gaston, K. J. (2021). Species distribution modelling is needed to support ecological impact assessments. Journal of Applied Ecology, 58(1), 21-26.
Bergstrom, D. M., Dickson, C. R., Baker, D. J., Winham, J., Selkirk, P. M., & McGeoch, M. A. (2021). Ecosystem collapse on a Sub-Antarctic island. In Ecosystem Collapse and Climate Change (pp. 13-25). Springer, Cham.
Dickson, C. R., Baker, D. J., Bergstrom, D. M., Bricher, P. K., Brookes, R. H., Raymond, B., ... & McGeoch, M. A. (2019). Spatial variation in the ongoing and widespread decline of a keystone plant species. Austral Ecology, 44(5), 891-905.
Baker, D. J., Clarke, R. H., & McGeoch, M. A. (2019). The power to detect regional declines in common bird populations using continental monitoring data. Ecological Applications, 29(5), e01918.
Baker, D. J., Garnett, S. T., O'Connor, J., Ehmke, G., Clarke, R. H., Woinarski, J. C., & McGeoch, M. A. (2019). Conserving the abundance of nonthreatened species. Conservation Biology, 33(2), 319-328.
Dickson, C. R., Baker, D. J., Bergstrom, D. M., Brookes, R. H., Whinam, J., & McGeoch, M. A. (2021). Widespread dieback in a foundation species on a sub‐Antarctic World Heritage Island: Fine‐scale patterns and likely drivers. Austral Ecology, 46(1), 52-64.
Relevant talks:
Landscape Decisions Fellow Dr David Baker introduces the project: Co-production of a software tool for field-scale species distribution modelling (fs-SDM) and mapping using local biodiversity records
Read more about Dr David Baker's fellowship here.
Dr David Baker delivered the #esiStateOfTheArt talk "Monitoring Biodiversity in a Rapidly Changing World” on Monday 25 October 1 - 2pm
Conservation management and policy decisions aimed at halting biodiversity loss and driving nature renewal should be underpinned by data on the distributions and health of species’ populations and habitats. The absence of these data results in poor decisions and missed opportunities and weakens the effectiveness of legal protections for biodiversity. This talk will highlight the importance and challenges of monitoring biodiversity in a rapidly changing world and argue that we must think more strategically about the biodiversity data being collected to ensure that we confront future biodiversity challenges with the necessary information to make effective decisions.
Click here to view the full video of the talk.

Dr Matthew Witt, Associate Professor in Natural Environment, was our Featured Academic for November 2021!
Click here to view his profile page
Recent publications:
We are delighted to announce that South West England has scored 65 out of 100 for ocean health in the first ever use of the Ocean Health Index+ (OHI+) in the UK. Read the full report by Matt Witt, Rachel Turner, Stephen Pikesley, Owen Exeter and Chris Kerry. View the University press release.
Thomas W Horton, Barbara A Block, Rachel Davies, Lucy A Hawkes, Duncan Jones, Hannah Jones, Keith Leeves, Niall Ó Maoiléidigh, David Righton, Jeroen van der Kooij, Dave Wall, Matthew J Witt, Evidence of increased occurrence of Atlantic bluefin tuna in territorial waters of the United Kingdom and Ireland, ICES Journal of Marine Science, 2021.
Read the UoE Press Release.
Rudd, J. L., Bartolomeu, T., Dolton, H. R., Exeter, O. M., Kerry, C., Hawkes, L. A., ... & Witt, M. J. (2021). Basking shark sub-surface behaviour revealed by animal-towed cameras. PloS one, 16(7), e0253388.
Thomas W Horton, Barbara A Block, Alan Drumm, Lucy A Hawkes, Macdara O’Cuaig, Niall Ó Maoiléidigh, Ross O’Neill, Robert J Schallert, Michael J W Stokesbury, Matthew J Witt, Tracking Atlantic bluefin tuna from foraging grounds off the west coast of Ireland, ICES Journal of Marine Science.
Rudd, Jessica L., Owen M. Exeter, Jackie Hall, Graham Hall, Suzanne M. Henderson, Christopher Kerry, Matthew J. Witt, and Lucy A. Hawkes. "High resolution biologging of breaching by the world’s second largest shark species." Scientific reports 11, no. 1 (2021): 1-5.
Pikesley, S. K., Solandt, J. L., Trundle, C., & Witt, M. J. (2021). Benefits beyond'features': Cooperative monitoring highlights MPA value for enhanced seabed integrity. Marine Policy, 134, 104801.
Project:
THUNNUS UK is a collaborative research project between The University of Exeter, The Centre for Environment, Fisheries and Aquaculture Science (Cefas) and the Tuna Research and Conservation Centre of Stanford University, USA and aims to provide a robust understanding of the ecology of Atlantic bluefin tuna (Thunnus thynnus) in waters of the British Isles. The project is supported by EU Interreg IV (FISH-INTEL), the Department for Food, Environment and Rural Affairs (Defra) and the European Maritime and Fisheries Fund (EMFF). Matt Witt and Lucy Hawkes are PI's for this project.
ESI Creative Exchange:
All Washed Up was a collaboration between Dr Matthew Witt and Rame Peninsula Beach Care (RPBC), a beach cleaning group from South East Cornwall.
Dr Matt Witt delivered the #esiStateOfTheArt talk "High-tech marine natural history: creating evidence to support conservation management” on Monday 29 November 1 - 2pm
In recent decades, the use of small high-tech electronic tags (known as biologging) has revolutionised our understanding of marine species movement, behaviour and distribution. Data from these tags are now increasingly used to aid marine management decision-making. In this talk I will describe some of the animal tracking projects active in our local waters looking to build knowledge on Atlantic bluefin tuna that see Devon and Cornwall waters as home. We will look at the inspiring migrations these animals make, the variety of technologies being used in the region and touch on emerging research that seeks to integrate tracking and genetic studies to deepen our understanding of these supreme migrants.
Click here to view the full video of the talk.

Caitlin DeSilvey, Professor of Cultural Geography at the Centre for Geography and Environmental Science, was our Featured Academic for January 2022!
Click here to view her profile page
Slected research, publications and events:
‘The Living Room’ at the Medical Museion at the University of Copenhagen explores what happens to museum objects when allowed to change and decay, inspired by the work of Professor Caitlin DeSilvey from the University of Exeter in collaboration with Professor Martin Grünfeld from the University of Copenhagen. Read the University of Exeter press release. A podcast featuring original sound work and collaborative conversations was created by Dr Bram Thomas Arnold, who worked with the Environment and Sustainability Institute during his 2019 Arts & Culture Fellowship as part of the ESI Creative Exchange Programme. In this podcast, Caitlin and Martin discuss their collaborative work on decay in relationship to Caitlin's book, Curated Decay: Heritage Beyond Saving, which received the 2018 University of Mary Washington’s Center for Historic Preservation book prize. Hear the RadioCIAMS podcast where Caitlin talks further about this book.
After Discourse: Things, Affects, Ethics has recently been published by Routledge, an edited collection based on the work Caitlin DeSilvey carried out with colleagues during her 2016-17 fellowship at the Centre for Advanced Study, Oslo.
The monograph “Heritage Futures: Comparative Approaches to Natural and Cultural Heritage Practices” draws on research undertaken over four years by an interdisciplinary, international team of researchers and partner organisations to explore the role of heritage and heritage-like practices in building future worlds. Caitlin DeSilvey is one of the authors. It is available for free download.
Thinking with Apples. Artists Simon Pope, William Arnold and James Fergusson will share their particular responses to this question on 18 January 2022 at CAST in Helston, over coffee and apple cake. Each of the invited artists has integrated apple-thinking into their creative practice, though in quite different ways. Professor Caitlin DeSilvey will chair their conversation about cider, scrumping and wild seedlings--opening up wider reflections on microbiopolitics, land tenure and genetic diversity (among other things).
Caitlin has been coordinating the ESI Creative Exchange since 2012. Our next February ESI State of the Art speaker will be Fulbright scholar MJ Sharp, collaborating with Professor Kevin Gaston on the project "Our disappearing darkness and recreating true night." MJ is a resident artist (September 2021 - May 2022) in the ESI Creative Exchange studio and will eventually be creating an immersive art installation.
The Landscape Futures team led by Caitlin DeSilvey published 'When Loss is More: From Managed Decline to Adaptive Release' in The Historic Environment: Policy and Practice special issue on Climate Change and the Historic Environment.
Prof Caitlin DeSilvey delivered the #esiStateOfTheArt talk/ Inaugural Lecture "Places as Paradigm Shifters” on Monday 31 January 4 - 5pm
Caitlin DeSilvey’s research has contributed to a gradual paradigm shift in conservation and heritage practice by exploring how cultural value and significance can be generated by working with natural processes of change and transformation, rather than against them. This focus on process, rather than preservation, has been articulated through collaborative development of a series of novel concepts, including ‘anticipatory history’, ‘curated decay’ and 'adaptive release'. In her inaugural lecture, she will reflect on how these ideas emerged from extended relationships with certain places and people over the last two decades, and suggest directions for new enquiry in a climate-changed future.

MJ Sharp, Fulbright Scholar 2021/ 2022 and ESI resident artist, delivered the State Of The Art talk for February 2022!
Click here to view her profile page
Read more about MJ Sharp's residency at the ESI Creative Exchange studio as part of the Creative Exchange Programme with Arts & Culture.
ESI resident artist MJ Sharp is currently planning future meet-ups of artists and scientists, similar to one organised last November, when ESI Early Career Researchers joined creative faculty and staff from Falmouth University, to share their work with one another and contemplate cross-disciplinary collaborations. All are welcome to join. No preparation needed. Please email MJCornwall@mjsharp.com with any questions or to be added to the mailing list for the group.
Ahead of MJ's #esiStateOfTheArt talk on 28 February, view her 'behind the scene' experience of photographing Lanyon Quoit at night in West Penwith, Cornwall (West Penwith was recently awarded International Dark Sky Park status by the International Dark-Sky Association).
View the amazing time-lapse photos of Trethevy Quoit at night and hear more about MJ's project on light pollution.
If you want to know how many shots go into preparing for the final photograph, view MJ Sharp's 'behind the scenes' video of Merry Maidens in West Penwith, Cornwall.
Another 'behind the scenes' experience of photographing Chun Quoit in West Penwith, Cornwall, a few nights before the full moon in February 2022.
MJ Sharp delivered the #esiStateOfTheArt talk "Our Disappearing Darkness and Recreating True Night” on Monday 28 February 3 - 4pm
A vanishingly small percentage of our evolutionary time as human beings has been spent in artificial light. For a large percentage of the world’s population, the experience of night is quickly becoming a boutique and privileged one. When we are robbed of night—from seeing the night sky that fueled the world’s mythologies to experiencing our own creaturely human adaptation to the dark— what are we missing?
Archeological evidence from some prehistoric megaliths in Cornwall suggests that people were visiting these sites in liminal light or at night. Could an artistic recreation of that experience help us better understand what we’re missing when we live our lives awash in light pollution—light pollution that isn’t even limited to earth at this point, but includes a truly staggering number of satellites already in orbit or slated to be in orbit in the unregulated space above earth.
Cornwall is remarkable both for its concentration of prehistoric sites and for its dark skies. Two of the seven designated Dark Sky Parks in the UK are in Cornwall—West Penwith recently joined Bodmin Moor with that status. I’m in Cornwall on a 2021/2022 Fulbright Scholar Award to explore our loss of darkness with Professor Kevin Gaston of the Environment and Sustainability Institute at the University of Exeter, Penryn Campus. The Environment and Sustainability Institute had the collaboration of artists and scientists in its very founding in the form of the Creative Exchange Programme, led by Professor Caitlin DeSilvey.
I will be talking about my artistic journey to recreate prehistoric darkness—from the germ of the idea to its current state, which has been immeasurably deepened by the input and insights of many generous artists, researchers, and scholars.
Click here to view the full video of the talk.

Dr Katie Shanks, an EPSRC David-Clarke Research Fellow, is our Featured Academic for March 2022!
Click here to view her profile page
Read more about her work here as it's updated throughout this month.
Dr Katie Shanks secured a highly competitive EPSRC David Clarke Fellowship. Katie will research bio-inspired optics to produce a new generation of solar energy technology. Read more. This was also featured by The Engineer.
Dr Shanks was awarded Supergen Energy Networks Hub's Early Career Researchers Seedcorn funding for "Feasibility study of coupling solar concentrators with photocatalytic technology for biomass photo-reforming to hydrogen and sustainable energy fuels." Katie is the Principal Investigator with Dr Nathan Skillen as collaborator. View the comic involving Dr Skillen with other researchers and artists (a team from The University of Manchester’s Supergen Bioenergy Hub) to explain Bioenergy.
Dr Katie Shanks was one of the speakers at the joint SUPERGEN SuperSolar Hub and the Institute of Physics webinar on the role of solar technologies in sustainable development with her talk "The Blue Square is so last year: Redesigning with artists how solar panels integrate and look."
She was also a speaker at the "Photovoltaics in the Circular Economy" event held by the SUPERGEN SuperSolar Hub earlier this month. The title of Dr Katie Shanks' talk was "Can Less Be More? - resource efficient energy using: Concentrator Photovoltaics, recycled PV, upcycled glass and biodegradable optics."
Other relevant publications:
- Shanks, K., Senthilarasu, S., & Mallick, T. K. (2015). White butterflies as solar photovoltaic concentrators. Scientific reports, 5(1), 1-10.
- Spalding, A., Shanks, K., Bennie, J., Potter, U., & Ffrench-Constant, R. (2019). Optical modelling and phylogenetic analysis provide clues to the likely function of corneal nipple arrays in butterflies and moths. Insects, 10(9), 262.
- Pickering, T., Shanks, K., & Sundaram, S. (2021). Modelling technique and analysis of porous anti-reflective coatings for reducing wide angle reflectance of thin-film solar cells. Journal of Optics, 23(2), 025901.
- Shanks, K., Knowles, A., Brierley, A., Baig, H., Orr, H., Sun, Y., ... & Mallick, T. (2019). An experimental analysis of the optical, thermal and power to weight performance of plastic and glass optics with AR coatings for embedded CPV windows. Solar Energy Materials and Solar Cells, 200, 110027.
The research done by Dr Katie Shanks has led to various creative affiliations:
- She recently gave a talk at the Contemporary Glass Society where she talked about the new start up Upcycled Glass Company with glass artist Ian Hankey and her plans to make solar optics.
- She earlier collaborated with The Art and Energy Collective on a Creative Exchange programme project called "Pretty Useful Solar Panel Artwork" to develop the aesthetics of solar photovoltaics (PV) creating a series of artworks that generate electricity.
- Further conversations with Art and Energy got them into moth eye optical structures, creating https://www.mothstoaflame.art/. Their much talked about art installation at the Glasgow Botanical Gardens was during COP26.
- Dr Katie Shanks is on the ESI’s creative exchange programme's development committee.
- Katie was interviewed for the Butterfly Blueprints documentary which is part of the NOVA series on PBS.
Dr Katie Shanks delivered the #esiStateOfTheArt talk "Bio-inspired Optics for 'invisible' Solar Technologies: Ordered vs Disordered patterns" on Monday 28 March 1 - 2pm
Nature has been manipulating and absorbing light energy over billions of years. Biomimicry of the unique nano-structures found within leaves, moth eyes and butterfly wings are attractive routes to enhancing solar technologies. Allowing for more compact, customised solar panels that can integrate more efficiently and aesthetically into buildings, vehicles and surrounding infrastructures. This is a significant step to expanding low carbon technologies towards the UK’s net zero targets and the interdisciplinary content invites unique discussions with artists and the public on the topic of energy and sustainability. Nature has however very complex patterns ranging from orderly lines to chaotic peaks, all affecting the direction and efficiency of light incident upon the material. Here I will present the key challenges and advantages facing advanced solar energy technologies, the solutions found within nature and the importance of “disordered” structures.
Click here to view the full video of the talk.

Clare Saunders, Professor in Environmental Politics, was our Featured Academic for April 2022! This was also her Inaugural Lecture
Click here to view her profile page
Read more about her work.
Prof Clare Saunders, Prof Brian Doherty and Dr Graeme Hayes, surveyed those involved with Extinction Rebellion's mass civil disobedience actions in London in 2019. Hear Clare talk about the Centre for the Understanding of Sustainable Prosperity (CUSP) funded study and its results https://bit.ly/3K0hTte.
Last year, Prof Saunders gave a talk at the Summer School Cognition & Climate by the Institut des sciences cognitives on Climate Change and Activism in the UK citing evidence from Extinction Rebellion https://bit.ly/3iPmGSz.
Prof Clare Saunders led the S4S Designing a Sensibility for Sustainable Clothing project which addresses environmental consequences of Fast Fashion. The team organised workshops, symposiums and presented their policy brief at the UK House of Lords hosted by Rt Hon Lord Swraj Paul, PC.
The House of Commons Environmental Audit Committee used recommendations from this S4S project for their report into the fashion industry “Fixing Fashion: Clothing consumption and sustainability" (pgs 52/53).
Reshaping Fashion Norms, a 2013-2015 ESI Creative Exchange Collaboration with Prof Clare Saunders, Irene Griffin & Sue Bamford paved way for the S4S Designing a Sensibility for Sustainable Clothing project.
Prof Clare Saunders and Dr Joanie Willett’s Political Studies Association blog “Global Climate Emergency: Changing how we think about clothing and sustainability,” discusses their S4S Designing a Sensibility for Sustainable Clothing project.
View the video recordings from Prof Saunders' 2020 ESI Think Tank 'Towards Fashion Justice: A UK-India Exchange' hosted by the Environment and Sustainability Institute and GW4 Water Security Alliance.
Recent publications on fashion:
Joanie Willett, Clare Saunders, Fiona Hackney and Katie Hill (2021) ‘The Affective Economy of Fast Fashion: Materiality, Embodied Learning and Developing a Sensibility for Sustainable Clothing’, Journal of Material Culture.
West, Jodie, Clare Saunders and Joanie Willett (2021) ‘A Bottom Up Approach to Slowing Fashion: Tailored Solutions for Consumers’, Journal of Cleaner Production.
Hackney, Fiona, Clare Saunders, Katie Hill and Joanie Willett (2021) ‘Changing the world not just our wardrobes: A sensibility for sustainable clothing, care and quiet activism’, Eugenia Paulicelli, Elizabeth Wissinger and Veronica Manlow (eds) The Routledge Fashion Studies Companion.
Recent publications on protest:
Clare Saunders (2021). ‘Who are Corbyn’s Supporters? Evidence from the Camborne rally, 8 August 2017’, British Politics.
Clare Saunders and Natalie Shlomo (2021). ‘A New Approach to Assess the Normalization of Differential Protest Participation’, Quality and Quantity. 55(1): 79-102.
Emily Rainsford and Clare Saunders (2021) ‘Caught in the Act of Political Participation: Surveying Political Activists’, SAGE Research Methods Cases.
Garland, Joshua, Clare Saunders, Cristiana Olcese and Delacey Tedesco (2021) ‘The influence of local opportunity structures on protest: Anti-fracking campaigns in the United Kingdom’, Social Movement Studies.
Silke Roth and Clare Saunders (Forthcoming) ‘Micro-level effects of political participation’ in Marco Guigni and Maria Grasso (eds) Oxford Handbook of Political Participation, Oxford: Oxford University Press.
Clare Saunders (Forthcoming) ‘Social networks and recruitment’, in Guigni, M. and Grasso, M. (eds) Routledge Handbook of Environmental Movements, London: Routledge.
Clare Saunders (Forthcoming) ‘Contentious Politics’ in Clive Barnett and Richard Ballard (eds) The Handbook of Social Change, London: Routledge
Professor Clare Saunders delivered the #esiStateOfTheArt talk "Adventures in meaningful social movement research" on Monday 25 April 4 - 5pm
This event is was organised by the Environment and Sustainability Institute (ESI) and the The Department of Politics.
Always keen to try to ‘save the world’ Clare Saunders has been an environmentalist academic for the past two decades. What began as idealistic passion to protect Mother Earth has become an endeavour to use robust research methods to understand and help environmental and social justice movements. In this talk, Clare will share insights on a number of dilemmas facing these movements. How might movement factions be united? How can movements best make decisions in ways true to their participatory ethos? Who takes to the streets and how we might move beyond the usual suspects? Which types of protests get the most media coverage? How do the public talk about protest? And are there better ways than protest to motivate people to engage in pro-environmental behaviour? Her talk will show why it is important for social movement research to have clear conceptual underpinnings, to construct effective sampling procedures and to produce research that is respectful of, and useful to, the activists who do the ‘real work’ of instigating progressive change.
Click here to view the full video of the talk.

Professor Ina Horlings, visiting academic from the University of Groningen, was our Featured Academic for May 2022!
Click here to view her profile page
Lummina (Ina) Horlings is affiliated as Prof. Socio-Spatial planning at the University of Groningen in The Netherlands. She has an educational background in social geography and finalised a PhD in Policy Sciences. Her research focus recently shifted to the topic of transformative citizens’ and community responses to climate change. She is an active fellow within the RSA as member of the Research Committee. She was also involved in the RSA Research Network on ‘Leadership in Urban and Regional Development’. Lummina Horlings participated in several INTERREG projects, co-coordinated the Marie Curie ITN program SUSPLACE on sustainable place-shaping (www.sustainableplaceshaping.net) , and is currently co-initiator and partner in the Marie Curie ITN project RECOMS on resourceful communities (www.recoms.eu). She edited several books, on Passion (2009), Vital Coalitions (2010), Leadership (2012), and the role of Culture in Regional Development (2015), and has written many peer-reviewed scientific articles. She is member of the academic board of the Platform Sustainable Society in Groningen.
Professor Horlings will deliver the #esiStateOfTheArt talk "Transforming places together: citizens and community engagement responding" on Tuesday 7 June 4 - 5pm
The simple evidence of global ambient temperature rises, changing rainfall patterns and more frequent and extreme weather events are indisputable and will severely impact communities and society as a whole. Incremental adaptation and coping strategies (such as building higher dikes) may not be enough to protect communities from greater risks in the future. Scholarly attention has therefore shifted to the concept of transformative adaptation to address the root causes of climate risks, shifting systems away from unsustainable, unjust and unequal trajectories. The key topic which will be discussed is how transformative citizens initiatives and resourceful communities take the lead in transforming places together. An emergence of citizens initiatives in the field of food, energy and nature can be witnessed taking matters in their own hand within the ‘do-it yourself’ democracy. This creates dilemma’s when collaborating with spatial planners. Networked movements such as transition towns and eco-villages contribute to the ‘up-, out- and deep-scaling’ of community strategies, while engaging in capacity building and different dimensions of transformation. A conclusion so far is that key conditions for the development of place-based transformative responses to climate change are capacity building, inclusive governance, place leadership, ‘inner’ transformation and the scaling of successful practices.
Click here to view the full video of the talk.
Professor Horlings will be holding a workshop for early career researchers titled "Social Science research for sustainability" on 10 June 4 - 6pm. Read more about this event.

Dr Aimee Murray, Lecturer in Microbiology, was our Featured Academic for June 2022!
Click here to view her profile page
Dr Aimee Murray won a NERC grant for "Exploring understudied aspects of antimicrobial resistance evolution to improve environmental pollution policy." With Co-Investigators Prof William Gaze, Prof Angus Buckling, Dr Mario Recker and Prof Barbara Kasprzyk-Hordern (University of Bath), along with support from the Environment Agency and Roche, the project will generate a publicly available database of the lowest antibiotic concentrations that increase AMR, both for individual compounds and environmental antibiotic mixtures in bacterial communities.
- Murray, A. K., Stanton, I., Gaze, W. H., & Snape, J. (2021). Dawning of a new ERA: Environmental Risk Assessment of antibiotics and their potential to select for antimicrobial resistance. Water research, 200, 117233.
- Murray, A. K., Stanton, I. C., Wright, J., Zhang, L., Snape, J., & Gaze, W. H. (2020). The ‘selection end points in communities of bacteria’(SELECT) method: a novel experimental assay to facilitate risk assessment of selection for antimicrobial resistance in the environment. Environmental health perspectives, 128(10), 107007.
- Stanton, I. C., Murray, A. K., Zhang, L., Snape, J., & Gaze, W. H. (2020). Evolution of antibiotic resistance at low antibiotic concentrations including selection below the minimal selective concentration. Communications biology, 3(1), 1-11.
- Murray, A. K. (2020). The novel coronavirus COVID-19 outbreak: global implications for antimicrobial resistance. Frontiers in microbiology, 11, 1020.
- Murray, A. K., Zhang, L., Yin, X., Zhang, T., Buckling, A., Snape, J., & Gaze, W. H. (2018). Novel insights into selection for antibiotic resistance in complex microbial communities. MBio, 9(4), e00969-18.
Dr Murray delivered the #esiStateOfTheArt talk "Not-so natural selection : the role of environment pollution in the rise of antimicrobial resistance" on Monday 27 June 1 - 2pm
View the event registration details here.
Antimicrobial resistance (AMR) is when microorganisms (including bacteria, fungi, viruses, and parasites) are unable to be effectively treated with antimicrobial drugs. Often referred to as the ‘silent pandemic’, bacterial AMR alone was associated with close to 5 million deaths in 2019. Most research focuses on AMR in clinical environments; however, in recent years, the role of the environment in the development, spread and transmission of AMR has become internationally acknowledged. One important area is whether antimicrobial pollution can enrich AMR in the aquatic environment. This talk will discuss previous evidence and future research into evolution of AMR at environmentally relevant antimicrobial concentrations, using an environmental risk assessment framework.
Click here to view the full video of the talk.

Prof Jane Wills (ESI Director and Professor of Geography) and Dr Rachel Turner (Senior Lecturer in Environmental Social Science), were our Featured Academics for September 2022!
View Prof Wills' profile page | View Dr Turner's profile page
- View their UKRI funded report "Towards a Sustainable Cornwall : State of the Doughnut" by Professor Jane Wills and Dr Rachel Turner et al on their collaboration with Cornwall Council to apply Kate Raworth's doughnut economics model to Cornwall.
- Dr Rachel Turner was part of the Doughnut Economics workshop with the Cornwall Doughnut Collective. It was organised by Helston Climate Action Group, Cornwall Council, University of Exeter and Café Disruptif. View the video here.
- View the report downscaling the idea of doughnut economics in Cornwall by Dr Rachel Turner, Amber Blundell, Claire Collins, Dr Owen Exeter and Prof Jane Wills.
- Professor Jane Wills talked to James Dundon from BBC Radio Cornwall about doughnut economics and sustaining the visitor economy and environment in Cornwall and the Isles of Scilly.
- Contributing to the first Annual Review of the Cornwall Plan (2021-2022), see the report by Professor Jane Wills, Claire Collins, Dr Rishika Mukhopadhyay and Dr Rachel Turner funded by the Cornwall Council and the British Academy.
- A paper by featured ESI academics of the month, Prof Jane Wills and Dr Rachel Turner, on downscaling doughnut economics for sustainability governance.
- Prof Jane Wills & Dr Rachel Turner's, "Localising and Decentralising Goal-Based Governance for Sustainability in England" project was funded by The British Academy for promoting inclusive sustainability.
- As part of the Annual Review and The British Academy project, the Civic Lantern workshop organised by Prof Jane Wills and Dr Rachel Turner identified top two goals for Cornwall. Read more.
Dr Turner and Prof Wills delivered the #esiStateOfTheArt talk "Localising and democratising goal-based governance for sustainability" on Monday 26 September 1 - 2pm
Sustainability is now promoted through goal-based governance at the international scale and there is growing recognition of the need to localise this approach. This raises questions about how existing institutions can engage in new and reflexive ways of working in order to tackle the novel challenges of the Anthropocene. There are also related debates about democratising the process of goal setting in order to increase public engagement and achieve significant change. Doing both requires statutory institutions working alongside a wide range of organisations that have complementary interests, roles and capacity, at a range of spatial scales.
This talk reports on an active research relationship with statutory organisations in Cornwall, UK, and it explores some of the opportunities and challenges of localising and democratising goal-based governance for socio-ecological sustainability. The talk aims to provide the intellectual tools and practical context for this work. It highlights: (1) the importance of institutional culture and relationships; (2) the need to adopt innovative methods to engage civic and civil society organisations; and (3) the importance of delivery for successfully localising and democratising goal-based governance. The findings provide insights that have relevance for other contexts as local leaders experiment to better recognise, reflect and respond to the social and ecological challenges of the Anthropocene.
Based on a research project funded by Cornwall Council and the British Academy, including Rishika Mukhopadhyay, Claire Collins and Elliot Honeybun-Arnolda.
Click here to view the full video of the talk.

Stefano Pascucci, Head of Department - Management (Business School) and Professor in Sustainability and Circular Economy, was our Featured Academic for October 2022!
View Prof Pascucci's profile page
Howard, M., Yan, X., Mustafee, N., Charnley, F., Böhm, S., & Pascucci, S. (2022). Going beyond waste reduction: Exploring tools and methods for circular economy adoption in small-medium enterprises. Resources, Conservation and Recycling, 182, 106345.
Borrello, M., Pascucci, S., Caracciolo, F., Lombardi, A., & Cembalo, L. (2020). Consumers are willing to participate in circular business models: A practice theory perspective to food provisioning. Journal of Cleaner Production, 259, 121013.
Stefano Pascucci was one of the speakers at the event “Sustainable Food: Innovative Approaches to Procurement and Surplus” to discuss sustainable & circular food systems.
Fischer, A., Pascucci, S., & Dolfsma, W. (2022). Designing a circular contract Template: Insights from the fairphone-as-a-Service project. Journal of Cleaner Production, 132487.
Professor Stefano Pascucci has recently been granted EU funding for the ‘InBestSoil’ project that focuses on actions to support practices and investments in soil health and food.
Tenorio, M. L. O., Pascucci, S., Verkerk, R., Dekker, M., & van Boekel, T. A. (2021). What does it take to go global? The role of quality alignment and complexity in designing international food supply chains. Supply Chain Management: An International Journal.
Borrello, M., Pascucci, S., & Cembalo, L. (2020). Three propositions to unify circular economy research: A review. Sustainability, 12(10), 4069.
Weituschat, C. S., Pascucci, S., Materia, V. C., Tamas, P., de Jong, R., & Trienekens, J. (2022). Goal frames and sustainability transitions: how cognitive lock-ins can impede crop diversification. Sustainability Science, 1-17.
This is part of the outcome of the EU-H2020 Diverfarming project.
Prof Stefano Pascucci was also involved in an International Summer School organised by the Tuscia University in Italy on Food, Landscapes and Ecosystems to design sustainable Futures in June.
Prof Pascucci gave a talk on “Community, Circularity and Innovative Practice” at the opening of the Creative Exchange exhibition Repair Acts in 2018. The exhibition highlighted the importance of repair in the circular economy and talk about the fantastic work that is happening around Cornwall to repair our much-loved items.
Prof Stefano Pascucci delivered the #esiStateOfTheArt talk “The socio-ecological foundations of the Circular Economy in the era of the Anthropocene” on Monday 31 October 1 - 2pm
Professor Stefano Pascucci is the Professor in Sustainability and Circular Economy at the University of Exeter Business School. He is also a Visiting Professor in Sustainable Business at the University of Auckland Business School.
The Anthropocene is defined as the ‘era of the humans’, an unprecedented geological period for which human actions have irreversible consequences on the Earth ecosystem. The idea of the Circular Economy (CE) has emerged as one of the most important ways in which we can respond to the challenges of the Anthropocene. It incorporates efforts to keep socio-economic activities within planetary boundaries, mimicking living systems and industrial ecologies. Scholars and practitioners have often depicted CE as a ‘vehicle’ to navigate the uncharted territory of the Anthropocene, and guide much needed socio-technological and organizational innovations for example by: (i) designing products for slowing, narrowing, and closing loops of resource use; (ii) delivering performance and functionality rather than ownership.
However, these interventions focus on business strategies and neglect the opportunity to better understand the socio-ecological foundations, and impacts, of CE. In addition, pioneers of CE tend to accept business logics and collective responsibility for externalities, rather than challenging them. An alternative approach would locate CE within the ambiguities and contradictions of capitalistic political economy, and to understand the eroding of natural ecosystems as a signal of the dysfunctions of unlimited production and consumption. This, in turn, points to the potential impossibility of CE as a complete solution to the challenges of the Anthropocene. It highlights the need to (re-)think our relation to nature and to prioritise understanding the intricate entanglement of social and ecological dimensions of the Anthropocene. It calls on us to go beyond the boundaries of current approaches to CE.
Click here to view the full video of the talk.

Dr Richard Sherley, Senior Lecturer in Marine Vertebrate Ecology, was our Featured Academic for November 2022!
Pacoureau N, Rigby CL, Kyne PM, Sherley RB, Winker H, Carlson JK, Fordham SV, Barreto R, Fernando D, Francis MP, et al (2021). Half a century of global decline in oceanic sharks and rays. Nature, 589(7843), 567-571.
This paper was featured on BBC News.
Kuepfer A, Sherley RB, Brickle P, Arkhipkin A, Votier SC (2022). Strategic discarding reduces seabird numbers and contact rates with trawl fishery gears in the Southwest Atlantic. Biological Conservation, 266, 109462-109462.
Sydeman WJ, Schoeman DS, Thompson SA, Hoover BA, García-Reyes M, Daunt F, Agnew P, Anker-Nilssen T, Barbraud C, Barrett R, et al (2021). Hemispheric asymmetry in ocean change and the productivity of ecosystem sentinels. Science, 372(6545), 980-983.
This was featured in The Conversation.
Dr Richard Sherley was awarded The Pew Fellowship in 2019 to discover if commercial fishing harms endangered penguin populations.
Sherley, R. B., Ladd‐Jones, H., Garthe, S., Stevenson, O., & Votier, S. C. (2020). Scavenger communities and fisheries waste: North Sea discards support 3 million seabirds, 2 million fewer than in 1990. Fish and Fisheries, 21(1), 132-145.
This was featured in The Scotsman.
Sherley, R. B., Ludynia, K., Dyer, B. M., Lamont, T., Makhado, A. B., Roux, J. P., ... & Votier, S. C. (2017). Metapopulation tracking juvenile penguins reveals an ecosystem-wide ecological trap. Current Biology, 27(4), 563-568.
This was featured in the Scientific American.
Sherley, R. B., Winker, H., Rigby, C. L., Kyne, P. M., Pollom, R., Pacoureau, N., ... & Dulvy, N. K. (2020). Estimating IUCN Red List population reduction: JARA—a decision‐support tool applied to pelagic sharks. Conservation Letters, 13(2), e12688.
Since 2001, Dr Richard Sherley has been running a long-term programme on African penguins in South Africa, hosting citizen science volunteers. Read the blog post from partner organisation Earthwatch. The results from that long-term study has fed into policy in South Africa for protecting areas around seabird colonies from fishing and has generated a lot of controversy.
Dr Richard Sherley delivered the #esiStateOfTheArt talk “Monitoring and mitigating marine megafaunal declines in the Anthropocene” on Monday 28 November 1 - 2pm
Human influences now pervade all ocean ecosystems and are (probably) driving rapid and widespread declines in marine biodiversity. But collecting data in the oceans is often challenging. Detecting and robustly quantifying species declines can often be difficult, particularly when dealing with long-lived, wide-ranging taxa. And correctly identifying the mechanism(s) underpinning those declines can be even more complex. Nevertheless, biodiversity conservation requires us to make management decisions, usually before we really have perfect understanding (and often agreement). In this talk, I’ll focus on the work that I’ve been doing with my research group and collaborators to understand the drivers of change in some marine vertebrate populations, assess the efficacy of potential management interventions, and develop tools that can (hopefully) help decision making in the face of uncertainty.
Click here to view the full video of the talk.

Dr Thomas O'Shea-Weller, Research Fellow with the Centre for Ecology and Conservation, was our Featured Academic for January 2023!
O’Shea-Wheller, T. A., Rinkevich, F. D., Danka, R. G., Simone-Finstrom, M., Tokarz, P. G., & Healy, K. B. (2022). A derived honey bee stock confers resistance to Varroa destructor and associated viral transmission. Scientific reports, 12(1), 1-19.
Read the University press release.
This research was also covered in Science "Scientists breed honey bees to fight deadly parasite." (April 2022)
O’Shea-Wheller, T. A., Hunt, E. R., & Sasaki, T. (2021). Functional heterogeneity in superorganisms: Emerging trends and concepts. Annals of the Entomological Society of America, 114(5), 562-574.
New Scientist featured Dr Thomas O'Shea-Wheller's article about honeybees showing a context-dependent rightward bias. Read the publication in Biology Letters.
Dr Thomas O’Shea-Wheller has recently been awarded grants from BDI (PI), AMCA (PI), and the IDSAI (Co-I), for projects investigating honey bee epidemiology, bumble bee ecology, and the use of AI in automated monitoring.
O’Shea-Wheller, T. A., Sendova-Franks, A. B., & Franks, N. R. (2015). Differentiated anti-predation responses in a superorganism. PloS one, 10(11), e0141012.. It featured on NOVA PBS, WIRED UK and BBC Radio 4.
Kennedy, P., Baron, G., Qiu, B., Freitak, D., ... O’Shea-Wheller, T. A., ... & Sumner, S. (2017). Deconstructing superorganisms and societies to address big questions in biology. Trends in Ecology & Evolution, 32(11), 861-872.
O’Shea-Wheller, T.A., Sendova-Franks, A.B., and Franks, N.R (2017). Variability in Individual Assessment Behaviour and its Implications for Collective Decision-Making. Proceedings of the Royal Society B. 284, 20162237.
Dr Thomas O'Shea-Wheller delivered the ESI State of the Art talk “Decoding the Superorganism: From Collective Cognition to Artificial Intelligence" on Monday 30 January 1 - 2pm
Colonies of social insects are biological benchmarks of adaptive self-organisation. Unlike human societies, they function absent centralised control, and are instead regulated primarily through interactions at the local level. This facilitates the emergence of complex collective behaviour from simple rules, while enhancing network flexibility and system redundancy. Notably, certain highly eusocial species function as integrated ‘superorganisms’—societies that are conceptually analogous to single multicellular bodies. Indeed, processes usually organised at a cellular level—such as the differentiation of germ and soma, or the formation of neural networks—may occur across discrete individuals, presenting unique opportunities for both observation and manipulation. Here, I outline the consequent utility of social insect models when addressing fundamental and applied challenges in biology. Additionally, I summarise how recent advances in artificial intelligence and automated tracking are enabling unprecedented insight into these complex systems.
Click here to view the full video of the talk.

Dr Michiel Vos, Senior Lecturer in Evolutionary Microbiology, based at the ESI and ECEHH, was our Featured Academic for March 2023!
Vos, M., Buckling, A., & Kuijper, B. (2019). Sexual selection in bacteria?. Trends in microbiology, 27(12), 972-981.
Stefanic, P., Belcijan, K., Kraigher, B., Kostanjšek, R., Nesme, J., Madsen, J.S., Kovac, J., Sørensen, S.J., Vos, M. and Mandic-Mulec, I., 2021. Kin discrimination promotes horizontal gene transfer between unrelated strains in Bacillus subtilis. Nature Communications, 12(1), p.3457.
Current NERC funding ‘Macro-evolution in microorganisms: marine-terrestrial transitions as a case-study for adaptive radiations in bacteria’ with Dr Daniel Padfield and external collaborators.
Winter, M., Buckling, A., Harms, K., Johnsen, P. J., & Vos, M. (2021). Antimicrobial resistance acquisition via natural transformation: context is everything. Current Opinion in Microbiology, 64, 133-138.
Soni, V., Vos, M., & Eyre-Walker, A. (2022). A new test suggests hundreds of amino acid polymorphisms in humans are subject to balancing selection. PLoS Biology, 20(6), e3001645.
Dickinson, A.W., Power, A., Hansen, M.G., Brandt, K.K., Piliposian, G., Appleby, P., O'neill, P.A., Jones, R.T., Sierocinski, P., Koskella, B. and Vos, M., 2019. Heavy metal pollution and co-selection for antibiotic resistance: A microbial palaeontology approach. Environment International, 132, p.105117
Dr Michiel Vos delivered the ESI State of the Art talk “Bacteria: Sex and Death" on Monday 27 March 1 - 2pm
Dr. Michiel Vos is a senior lecturer in Evolutionary Microbiology based at the ECEHH and ESI. His interests range from fundamental processes shaping the evolutionary diversification of bacteria, specifically though Horizontal Gene Transfer (HGT), to more applied questions relating to the virulence and antibiotic resistance of opportunistic pathogens in the environment. His presentation will cover both areas of research, from ‘bacterial sex’ (HGT) to the ecology of bacterial pathogens.
Click here to view the full video of the talk.

Dr Onna Van Den Broek, Lecturer in Sustainable Business and Politics, was our Featured Academic for October 2023!
- Baudoin, L., Simone, C., Nava, L., Poggioli, N., & van der Broek, O. M. (2022). Imagining a Place for Sustainability Management: An Early Career Call for Action. Journal of Management Studies, doi, 10.
Read the blog post about sustainability management which reflects on how business schools can to do more in understanding and solving global social-ecological challenges.
Onna also organised an event on 'Sustainability Management: Talking with our Deans.' Watch the full video recording here. - Read the paper by Dr Onna Van Den Broek and Dr Adam Chalmers, on "Financial volatility and public scrutiny as institutional determinants of financial industry firms' CSR" for which they won the Business and Politics journal's David P. Baron Award.
- Dr Onna Van Den Broek won the “outstanding" thesis award for her PhD dissertation at King's College London.
- van den Broek, O. M. (2022). How Political Actors Co‐Construct CSR and its Effect on Firms' Political Access: A Discursive Institutionalist View. Journal of Management Studies.
Read her blog post here. - Van den Broek, O. M., & Klingler-Vidra, R. (2021). The Sustainable Development Goals (SDGs) as a North Star: how an intermediary network retrofits and socializes the SDGs. Regulation & Governance, 1-19.
- van den Broek, O. M. (2023). Why I Hesitate to Have a Child: Eco-Anxiety and Reproduction Concerns. Business & Society, 0(0).
Dr Onna Van Den Broek will organise an event on reproductive justice at the ESRC Festival of Social Science on 12 November. - Van den Broek, O. (2021). Soft Law Engagements and Hard Law Preferences: Comparing EU Lobbying Positions between UN Global Compact Signatory Firms and Other Interest Group Types. Business and Politics, 23(3), 383-405.
- Dr Onna Van Den Broek has been awarded a Marie Curie grant, starting next year at the Copenhagen Business School, for a period of two years.
- Dr Onna Van Den Broek is the social media editor for the Journal of Business Ethics. Previously she was the social media editor for the Social Issues in Management (SIM) division of the Academy of Management. She was part of the #ThinklistNext21 at the University of Bath. It was a list of the most influential and responsible business scholars.
Dr Onna Van Den Broek delivered the ESI State of the Art talk “The battle of ideas in organizing for sustainability” on Monday 30 October 1 - 2pm.
Sustainability challenges, such as climate change, migration, racism, poverty, or exploitation of labour and human rights in supply chains, have a scale and complexity that neither the public nor the private sector alone cannot fix. But it is unclear which role corporations play in (re)thinking—and governing—what constitutes a socially just transition to a sustainable economic system. This talk will explore the role of corporate power in sustainability solutions and governance, focussing particularly on the existence of different, co-existing ideas about how to organize and regulate for sustainability, how to communicate and socialize this, and the effects on institutions and policies. The talk will end by discussing alternative ideas and reimagining different pathways to sustainability.
Click here to view the full video of the talk.
Dr Elze Hesse, Senior Research Fellow at the Centre for Ecology and Conservation, was our Featured Academic for November 2023!
Hesse E, O’Brien S, Bayer F, Lujan AM, van Veen EM, Hodgson DJ, Buckling A (2021). Stress causes interspecific facilitation in a compost community. Ecology Letters 24: 2169-2177.
Hesse E, O’Brien S, Tromas N, Bayer F, Lujan AM, van Veen EM, Hodgson DJ, Buckling A (2018). Ecological selection of siderophore-producing microbial taxa in response to heavy metal contamination. Ecology Letters 21: 117-127.
Hesse, E., Padfield, D., Bayer, F., Van Veen, E. M., Bryan, C. G., & Buckling, A. (2019). Anthropogenic remediation of heavy metals selects against natural microbial remediation. Proceedings of the Royal Society B, 286(1905), 20190804.
Hesse, E., Rees, M., & Müller-Schärer, H. (2008). Life-history variation in contrasting habitats: flowering decisions in a clonal perennial herb (Veratrum album). The American Naturalist, 172(5), E196-E213. Faculty 1000 ‘must read’.
Hesse, E., & Pannell, J. R. (2011). Density‐dependent pollen limitation and reproductive assurance in a wind‐pollinated herb with contrasting sexual systems. Journal of Ecology, 99(6), 1531-1539.
As part of her UKRI Future Leaders Fellowship, Dr Elze Hesse is organising three “Social Microbes” residencies in collaboration with Then Try This. The project explores the social behaviours of microbes, and how these behaviours could be changed through various interventions, in order to bring benefits like helping us to clean up mine waste, or helping crops to take up less heavy metals from polluted soil. Read more.
Dr Hesse was part of the art and science collaborations via the Creative Exchange programme (now relaunched as the FX Creative Exchange):
- Contaminated Soils in Ceramics. This Creative Exchange project forged links between scientist Dr Elze Hesse and ceramic artist Fleur Winter with the aim to bridge their fields through the use of research material and fired ceramics.
- Should I Stay or Should I Go? This exhibition developed by Dr Tim Cockerill and Dr Elze Hesse showcased a stunning series of large-scale macro photographic images which visualised how social and environmental cues can affect how bacteria swarm collaboratively.
Dr Elze Hesse was invited on BBC Radio 4 to talk about her work on microbial communities inhabiting mine-degraded soils as part of the programme 'Costing the Earth.'
* Banner credit Dr Tim Cockerill from an art-science collaboration with Dr Elze Hesse, “Should I Stay or Should I Go” as part of the ESI Creative Exchange Programme.
Dr Elze Hesse delivered the ESI State of the Art talk “Living soils – the role of microbes in soil health” on Monday 27 November 1 - 2pm.
Mining is a major cause of soil degradation, having left a substantial global footprint. The release and remobilization of toxic metals into the environment as a result of mining activities can pose serious long-term threats to ecosystem- and human health. Bacteria contribute to many geological processes, including the biogeochemical cycling of metals. Hence, researchers have started using bacteria to remediate mine waste, but mainly in the context of single species. In this talk, I will explore whether we can exploit social interactions in bacterial communities to aid in the clean up toxic mine waste.
Click here to view the full video of the talk.

Dr Joanie Willett, Associate Professor in Politics, was our Featured Academic for January 2024!
Dr Joanie Willett explores how decentralisation has improved relationship between local government and their citizens in two Appalachian communities, looking at lessons that we can draw in the UK from the US. Read the full blog post.
Read Dr Willett’s article in ‘The Loop,’ the European Consortium for Political Research’s Science Blog, titled “Local government in the US: lessons for a decentralising UK.”
Dr Joanie Willett won the 2022/2023 Fulbright scholarship to study the project ‘A Spatial Economy of the Complex Adaptive Region Assemblage: Understanding The Relationship between the Environment and Rural Economies.’ She was based out of Virginia Tech, in Blacksburg, Virginia.
Her edited textbook An Introduction to UK Politics: Place, Pluralism and Identities will be released in spring 2024. This current project formed part of Joanie’s Fullbright Scholarship.
Dr Joanie Willett was the "Big Guest" on BBC Radio Cornwall with Julie Skentelbery last year where she talked about her work.
Dr Willett is the co-director of the Institute of Cornish Studies, a former trustee of the Political Studies Association, co-convenor of the PSA Local Government and Politics specialist group, and helps to coordinate EdgeNet, a Regional Studies Association network which explores questions of peripheral and rural development.
'The State of Cornwall' is a report from the Institute of Cornish Studies, about the social and economic issues affecting Cornwall today. The report is authored by Phoebe Lawlor, a postgraduate researcher at the University of Exeter; Dr Joanie Willett, ESI academic and Director of the Institute of Cornish Studies; and Professor Malcolm Williams, who leads the Institute's new Social and Economic Research Unit.
Dr Joanie Willett did a collaborative project “Painting a Parish Future” with ecological artist Peter Ward, exploring the importance of ecological engagement to political process through interdisciplinary workshops and research, as part of the Creative Exchange Programme at the ESI.
Dr Joanie Willett delivered the ESI State of the Art talk “Is Politics More-than-Human? How American (local) Government is Created by the Environment” on Monday 29 January.
In the discipline of politics, we tend to view the environment along a spectrum of something that humans have to make decisions about protecting; to environmental disasters that limit human action, and require political responses. This talk questions these assumptions, asking to what extent to the nature and structures of our politics are entangled and co-evolving with the environments that we live in, and the kinds of economic opportunities that local geologies, ecologies, and geographies afford. The paper draws on ethnographic research in communities the mountains of southern Appalachia, and in the Cornish gold mining town of Grass Valley, California to explore the extent to which the natural environment, communities, and polities, are inseparably entangled.
Click here to view the full video of the talk.

Dr Sarah Nelms, Lecturer at the Centre for Ecology and Conservation and part of the Exeter Marine network, was our Featured Academic for February 2024!
S. E. Nelms, T. S. Galloway, B. J. Godley, D. S. Jarvis, P. K. Lindeque, Investigating microplastic trophic transfer in marine top predators. Environ Pollut 238, 999-1007 (2018). Read the lay summary here.
S. E. Nelms et al., Microplastics in marine mammals stranded around the British coast: ubiquitous but transitory? Sci Rep 9, 1075 (2019). Read the lay summary here.
Nelms, S. E., Duncan, E. M., Patel, S., Badola, R., Bhola, S., Chakma, S., ... & Koldewey, H. (2021). Riverine plastic pollution from fisheries: Insights from the Ganges River system. Science of the Total Environment, 756, 143305.
Nelms, S. E., Eyles, L., Godley, B. J., Richardson, P. B., Selley, H., Solandt, J. L., & Witt, M. J. (2020). Investigating the distribution and regional occurrence of anthropogenic litter in English marine protected areas using 25 years of citizen-science beach clean data. Environmental Pollution, 263, 114365.
Nelms, S. E., Coombes, C., Foster, L. C., Galloway, T. S., Godley, B. J., Lindeque, P. K., & Witt, M. J. (2017). Marine anthropogenic litter on British beaches: a 10-year nationwide assessment using citizen science data. Science of the Total Environment, 579, 1399-1409.
"The Tale of the Turtle and the Plastic Jellyfish" by Dr Sarah Nelms. Professor Penny Stories are a series of children’s books written by staff and students of the University of Exeter’s College of Life and Environmental Sciences based in Penryn, Cornwall. Each with a unique style and appropriate for a range of ages, these stories bring scientific research and natural history to life—from microbiology to animal behaviour and conservation.
"Sea turtles and the perils of plastic" by Dr Sarah Nelms and colleagues in Current Conservation.
Dr Sarah Nelms is among those Exeter Marine colleagues who were awarded Visiting Fellowships with Plymouth Marine Laboratory, highlighting the outstanding contribution of their collaborative science. Read more.
Dr Sarah Nelms delivered the ESI State of the Art talk “Marine litter, microplastics and marine vertebrates” on Monday 26 February.
Growing evidence suggests that anthropogenic litter, particularly plastic pollution, represents a highly pervasive and persistent threat to global marine ecosystems. An understanding of where debris originates from, where it ends up and how it affects marine habitats and species is crucial for informing policies aimed mitigating the harm it may cause. In this talk, I will give an overview of the various projects I have worked on to map marine litter and explore the extent and impacts of plastic ingestion on marine vertebrates, such as turtles and marine mammals. I will also highlight some of the key research questions that I hope to address in the future.
Click here to view the full video of the talk.

Prof Peter Cox, Director of the Global Systems Institute and Professor of Climate System Dynamics in Mathematics, was our Featured Academic for March 2024!
Cox, P.M., Williamson, M.S., Friedlingstein, P., Jones, C.D., Raoult, N., Rogelj, R., Varney, R.M., 2024. Emergent constraints on carbon budgets as a function of global warming. Nature Communications 15, 1885 (2024).
Moore, J., Argles, A., Cox, P., 2023. A theory of demographic optimality in forests. Science Reports, 13, 18712.
Argles, A., Moore, J.R., Huntingford, C., Wiltshire, A.J., Jones, C.D., Cox, P.M., 2020. Robust Ecosystem Demography (RED): a parsimonious approach to modelling vegetation dynamics in Earth System Models. Geoscientific Model Development, 13, 4067–4089, 2020.
Cox, P., Pearson, D., Booth, B. et al. Sensitivity of tropical carbon to climate change constrained by carbon dioxide variability. Nature 494, 341–344 (2013).
Cox P.M., Betts R.A., Collins M., Harris C., Huntingford C., Jones C.D., 2004. Amazon dieback under climate-carbon cycle projections for the 21st century. Theoretical and Applied Climatology, 78, 137-156.
Parry, I., Ritchie, P., Cox, P., 2022. Evidence of Amazon localised rainforest dieback in CMIP6 models. Earth System Dynamics, 13, 1667–1675.
View the press release.
Peter has been named as a highly-cited researcher every year from 2014 onwards.
He wrote the following article as a guest post on CarbonBrief "Could climate change and deforestation spark Amazon ‘dieback’?"
Prof Peter Cox was featured with Sir David Attenborough on CBC News "The truth about Climate Change."
He is a member of the UK Government's Defra Scientific Advisory Council.
Peter Cox was a lead author on the 4th, 5th and 6th Assessment Reports of the Intergovernmental Panel on Climate Change.
Prof Peter Cox delivered the ESI State of the Art talk “Adventures in Global Vegetation Modelling” on Monday 25 March.
Trained as a physicist, I cut my post-PhD teeth in the 1990s trying to model the response of vegetation to global climate change at the then new, Hadley Centre for Climate Prediction and Research. The model I designed, called “TRIFFID”, was used in the first climate model projections to include vegetation and the carbon cycle as interactive elements. Those projections suggested that climate change could lead to dieback of the Amazon rainforest, and predicted an acceleration of climate change due to the release of carbon from soils and vegetation under global warming (Cox et al., 2000).
That result was alarming to us and many others, but we consoled ourselves with the fact that our model produced a much larger land carbon cycle feedback than the other models that were developed shortly afterwards (Friedlingstein et al., 2006). We could also see evidence that our model produced unrealistically large variations in the year-to-year increase in atmospheric CO2, which was consistent with our modelled tropical forests being too sensitive to climate (Cox et al. 2013). My colleagues and I gave a metaphorical sigh of relief.
But things just got scary again. Firstly, ground-based measurements of tree growth-rates suggested that the Amazon forest was absorbing carbon at a decreasing rate (Hubau et al., 2020). Then the latest generation of Earth System Models started to show more agreement that climate change could result in abrupt loss of forest or ‘localised dieback’ (Parry et al., 2022). Large parts of the real Amazon also suffered their worst recorded drought in 2023. Many would now agree the Amazon rainforest is very vulnerable to the combination of climate change and deforestation (Flores et al., 2024).
Nevertheless, accurately predicting how the Amazon rainforest will respond to climate change undoubtedly requires much more sophisticated vegetation models than we have used to date. First generation models like “TRIFFID” attempt to model the large-scale properties of the vegetation (e.g. vegetation carbon, leaf area index), without explicitly modelling the growth or death of individual plants. In fact, those models know nothing at all about the varying size of trees in forests, and therefore cannot make use of incredibly detailed forest inventory data.
My research team at Exeter set out to remedy that situation, by producing the ‘Robust Ecosystem Demography (RED)’ which models the number of tree as a function of tree mass (Argles et al., 2020). RED is therefore able to make sense of forest inventory, and can be used to interpret the size structure of trees in a forest in terms of the ratio of tree mortality to tree growth-rate (Moore et al., 2020). In fact this ratio is remarkably constant across different forest types and in different locations, a universality that we call ‘demographic optimality’ (Moore et al. 2023). We are still trying to understand how that optimality is arrived at, and what it might mean for the resilience of tropical forests.
Click here to view the full video of the talk.

Dr Maike Hamann, Senior Lecturer in Development and Sustainability at the Centre for Geography and Environmental Science (CGES), was our Featured Academic for April 2024!
One of the themes of Maike's research is “futures” or "futuring." Read the “toolkit” paper she led on participatory scenario planning, which is related to her state of the art presentation on 29 April.
Another of Maike's research themes is around urban sustainability, specifically nature in cities. Read her most recent paper "The intersection of justice and urban greening: Future directions and opportunities for research and practice" and blog post on this topic.
Related to her presentation is the idea of “Seeds of Good Anthropocenes”. The idea is that “pockets of the future” already exist in the present, in the form of projects, ideas, technologies, organizations etc. that are doing things differently and better for people and the planet. We can then build upon these initiatives towards more sustainable and equitable futures. Read the paper "Scenarios of Good Anthropocenes in southern Africa" where Maike and colleagues piloted the Seeds idea in a futuring workshop in Cape Town.
'Global modeling of nature’s contributions to people', Science.
'The bii4africa dataset of faunal and floral population intactness estimates across Africa’s major land uses,' Scientific Data.
Dr Maike Hamann delivered the ESI State of the Art talk “Ditching dystopia: The case for more positive, participatory, and place-based futuring” on Monday 29 April.
The future is bleak. At least, that’s the dominant narrative, the easy answer. Climate change, inequality, pandemics, and wars – there does not seem to be much to be positive about. And yet, we know that negative thinking is bad for us, and often counterproductive in achieving sustainability goals. In this talk, I explore the power of futuring, which is the purposeful and systematic thinking about and planning for the future. Drawing on examples from southern Africa, I argue for rebellious positivity in futuring, and illustrate the value of participatory processes and collective imagining as a method for creating transformative experiences. Finally, focusing on urban systems, I outline the importance of anchoring future visions in specific places and contexts, to challenge dominant Global North ideas of the future city.
Click here to view the full video of the talk.

Dr Kate Littler, Senior Lecturer in Geology in the Department of Earth and Environmental Sciences, was our Featured Academic for May 2024!
Crane, R., Laing, C., Littler, K., Moore, K., Roberts, C., Thompson, K., ... & Scourse, J. (2024). Deep-sea mining poses an unjustifiable environmental risk. Nature Sustainability, 1-3.
Read the University press release here.
Mariani, E., Kender, S., Hesselbo, S. P., Bogus, K., Littler, K., Riding, J. B., ... & Dickson, A. J. (2024). Large Igneous Province control on ocean anoxia and eutrophication in the North Sea at the Paleocene–Eocene Thermal Maximum. Paleoceanography and Paleoclimatology, 39(4), e2023PA004756.
Dr Kate Littler is a reviewer for Paleoceanography and Paleoclimatology; Nature; Nature Geoscience; Geology; Geological Magazine; Palaeogeography, Palaeoclimatology, Palaeoecology; The Geological Society of America Bulletin; DFG and NERC.
Westerhold, T., Marwan, N., Drury, A. J., ... Littler, K., … & Zachos, J. C. (2020). An astronomically dated record of Earth’s climate and its predictability over the last 66 million years. Science, 369(6509), 1383-1387.
McClymont, E. L., Ford, H. L., Ho, S. L., ... Littler, K., … & White, S. (2020). Lessons from a high CO 2 world: an ocean view from~ 3 million years ago. Climate of the Past Discussions, 2020, 1-27.
Graham, O., Witkowski, C., Littler, K., & Naafs, D. (2023, September). Reconstructing PCO2 in the Deep Geological Past Using a General Phytoplankton Biomarker. IMOG 2023 (Vol. 2023, No. 1, pp. 1-2). European Association of Geoscientists & Engineers.
Read more about Dr Littler's project on decoding the ancient India monsoon. Its behaviour and stability under ongoing anthropogenic climate change is a matter of heated debate.
Beasley, C., Kender, S., Giosan, L., Bolton, C. T., Anand, P., Leng, M. J., ... & Littler, K. (2021). Evidence of a South Asian proto‐monsoon during the Oligocene‐Miocene transition. Paleoceanography and Paleoclimatology, 36(9), e2021PA004278.
Dr Kate Littler delivered the ESI State of the Art talk “Tales from the ancient Indian monsoon” on Tuesday 21 May.
The Indian (or South Asian) Monsoon is one of the most powerful meteorological phenomena on the planet, responsible for providing drinking and irrigation water to over a billion people. But its future stability under anthropogenic climate change is uncertain, with different computer models giving different answers to the question “what will happen to the monsoon in a warmer world?”. One way we can try to better understand the Indian monsoon is to interrogate the geological record for clues as to its past stability. In this talk I will show you how ancient mud from the bottom of the sea, combined with geochemistry and microfossils, can shed light on past monsoon behaviour. How did the monsoon respond to the large-scale growth of the Northern Hemisphere ice sheets 2.7 million years ago? How strong was the monsoon the last time we had ~400 ppm of CO2 in our atmosphere?
Please note this talk was not recorded as some unpublished papers were mentioned.